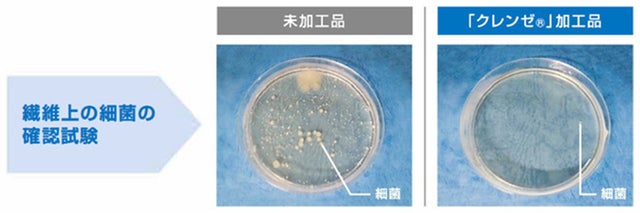

プロジェクト実行者
ストーリー
- “ハンカチなのに正方形じゃない!?” 二つ折りに出来て使いやすい「ハーフタオルハンカチ」
- 国内の紡績工場で作られた空洞のある糸を使い、柔らかさと軽量感を実現
- 抗菌・抗ウイルス機能繊維加工技術「クレンゼ®」を施した外出必需品のご提案
毎日持ち歩きたくなるタオルハンカチのご提案

トイレで手を洗った後、こんな状態のままな人、いませんか?
この度ご提案させていただく『NOVUS®ハーフタオルハンカチ』は、今までハンカチを持ち歩いていなかった方に“こんなハンカチだったら持ち歩きたい”と思ってもらえるように思案し、生まれたプロダクトです。
かく言う私も、実はハンカチを持ち歩かないタイプでした。
そして昨今の状況から、

と困っている方も多いのではないでしょうか。
通勤や通学など、外出の機会にはぜひ!この『NOVUS®ハーフタオルハンカチ』を持ち歩いていただければと思います。
ハーフタオルハンカチの魅力

折りたたむとどうしてもかさばってしまうタオルハンカチ。
これまで正方形が常識だったタオルハンカチを半分のサイズにし、センターに折り目のある二つ折りの構造にすることで、折りたたんでもかさばらない仕様にしました。

従来の正方形のタオルハンカチを比べるとこんなにコンパクトです。

そのため、ズボンのポケットにもスッキリと収納することが可能です。

また、乾いた状態であれば、ハンカチの上にマスクをのせ、半分にたたむとマスクケースのように使うこともできます。持ち運びはもちろん、外出先での食事など一時的にマスクを外す際に衛生的にしまえるので、お出かけに1枚持っておくと便利なアイテムになっています。

使いやすさを追求するため特殊構造糸を使用

サイズを見直した「NOVUS®ハーフタオルハンカチ」ですが、さらに使いやすさを追求するため、国内の紡績工場で作られた空洞のある糸をパイル部分に用い、柔らかさと軽量感を実現しました。
「CLEANSE®/クレンゼ®」とは?
ハンカチについた菌やウイルス、気になりますよね?
このハーフタオルハンカチには、クレンゼ®を用いて抗菌・抗ウイルス加工を施しているので、日々の持ち歩きにもってこいの仕様になっています。

クレンゼ®とは、固定化抗菌成分 「Etak®/イータック」 を繊維表面に強力に固定化する倉敷紡績株式会社(クラボウ)独自の抗菌・抗ウイルス機能繊維加工技術のことで、下記3つの特長を持っています。※1
◎抗菌・抗ウイルス
繊維上の特定のウイルスの数を減少させ、特定の細菌の増殖を抑制。生乾きの嫌なニオイの原因となる細菌をはじめ、約20種類の微生物(細菌・真菌)やウイルスに対する効果を確認しています。
◎優れた洗濯耐久性
家庭洗濯50回後も繊維上の特定のウイルスの数を減少させることを確認しています。
◎安全性
口腔衛生用抗菌剤をベースにし、各種試験で高い安全性を確認。
クレンゼ®に関する情報はこちらも合わせてご参照ください。
https://www.kurabo.co.jp/cotton/mobile_cleanse/
NOVUS®ハーフタオルハンカチの仕様

サイズ: 約25×12.5cm
素材: 綿100%
原産国: 日本製

今回のプロジェクトではこの2色をリターンとして用意しています!
リターンについて
1枚ずつパッケージングしてお届けします。
何枚あっても困らない“もらって嬉しい”ハンカチは、日頃の感謝の気持ちとしてちょっとしたギフトにもオススメです。

① NOVUS®ハーフタオルハンカチ × 各1枚 計2枚セット
→ 早割 2,376円(10% OFF)
② NOVUS® ハーフタオルハンカチ × 同色2枚セット
→ 早割 2,376円(10% OFF)
③ NOVUS® ハーフタオルハンカチ × 各2枚 計4枚セット
→ 超早割 3,920円(19% OFF)
→ 早割 4,114円(15% OFF)
④ NOVUS® ハーフタオルハンカチ × 同色5枚セット
→ 超早割 4,752円(20% OFF)
⑤ NOVUS® ハーフタオルハンカチ × 各柄10枚ずつ 計20枚セット
→ 超早割 16,830円(25% OFF)
⑥ NOVUS® ハーフタオルハンカチ × 同色50枚セット
→ 超早割 41,580円(25% OFF)
※価格は全て、送料・税込み表記としております。
※いずれも数量限定となります。
スケジュール
プロジェクト期間終了後、6月上旬から順次発送を開始し、6月末までには皆さまへお届けできるよう進めて参ります。
さいごに
このプロジェクトを進めていくにあたり、周囲の人にハンカチの使用頻度を聞いて回ったのですが、男性で私のような“自然乾燥派”を貫いている人が結構多く、妙な共感で盛り上がることが多々ありました。笑
10年以上タオルの仕事に携わっていながら、なんとなく持ち歩くのが面倒に感じていた私ですが、このハーフタオルハンカチを使いだしてからは、マスクケースとして使える便利さから、毎日忘れることなく持ち歩いており、ちゃんと手を拭く習慣ができました。
(ちゃんと持ち歩いている人からすると、なんの話やねんって感じですが。)
身近にこんな旦那さん・お子さんがいる女性は温かい目でこのハーフタオルハンカチを勧めていただけると幸いです。
実行者紹介

『NOVUS®』
1864年創業、150余年の歴史を持つ繊維専門商社が手掛けるライフスタイルブランド。
NOVUS(ノーヴス)はラテン語で「新しい」「新鮮な」という意味で、「Innovation(革新)」や「Novel(小説)」の語源でもあります。
今の時代に適した機能・デザインを持ちあわせた製品をお届けしていきます。
リスク&チャレンジ
■本プロジェクトを通して想定を上回る皆様からご支援を頂き、現在進めている環境から量産体制を更に整えることができた場合、正規販売価格が販売予定価格より下がる可能性もございます。 ■開発中の製品につきましては、デザイン・仕様が一部変更になる可能性もございます。 ■ご注文状況、使用原料の供給状況、製造工程上の都合等により出荷時期が遅れる場合があります。出荷時期が遅れそうな場合は事前に連絡いたします。あらかじめご了承ください。 ※1 クレンゼ®に関して ■抗菌・抗ウイルス加工は病気の治療や予防を目的とするものではありません。 抗ウイルス加工は、ウイルスの働きを抑制するものではありません。 抗菌性、抗ウイルス性の評価に関しましては、クラボウの独自評価によるものです。 ■「CLEANSE®/クレンゼ®」は、倉敷紡績株式会社の登録商標です。 ■「Etak®」は、株式会社キャンパスメディコの登録商標。 広島大学大学院 二川浩樹教授が口腔内の治療や洗浄時に使われている消毒薬をベースに研究し、商品化された成分です。
サポーターからの応援コメント
文章のトップに戻る
応援購入する
このプロジェクトはAll in型です。目標金額の達成に関わらず、プロジェクト終了日の2021年05月27日までに支払いを完了した時点で購入が成立します。
【早割】NOVUS ハーフタオルハンカチ 各色1枚 計2枚セット

2,376円(税込)
“洗い替えに便利な2枚セット”
[一般販売予定価格 2,200円+送料440円から10%OFF]
【早割】NOVUS ハーフタオルハンカチ 同色2枚セット

2,376円(税込)
“洗い替えに便利な2枚セット”
グレー/ブラウンどちらかお選びいただけます。
[一般販売予定価格 2,200円+送料440円から10%OFF]
【超早割】NOVUS ハーフタオルハンカチ 各色2枚 計4枚セット

3,920円(税込)
“家族みんなで使える4枚セット”
[一般販売予定価格 4,400円+送料440円から19%OFF]
【早割】NOVUS ハーフタオルハンカチ 各色2枚 計4枚セット

4,114円(税込)
“家族みんなで使える4枚セット”
[一般販売予定価格 4,400円+送料440円から15%OFF]
【早割】NOVUS ハーフタオルハンカチ 同色5枚セット

4,752円(税込)
“お得なまとめ買い5枚セット”
[一般販売予定価格 5,500円+送料440円から20%OFF]
【超早割】NOVUS ハーフタオルハンカチ 各色10枚 20枚セット

16,830円(税込)
“サークルやクラブチームで使えるまとめ買い20枚セット”
[一般販売予定価格 22,000円+送料440円から25%OFF]
【超早割】NOVUS ハーフタオルハンカチ 同色50枚セット

41,580円(税込)
“サークルやクラブチームで使えるまとめ買い50枚セット”
[一般販売予定価格 55,000円+送料440円から25%OFF]
「Makuake(マクアケ)」は、実行者の想いを応援購入によって実現するアタラシイものやサービスのプラットフォームです。このページは、 プロダクトカテゴリの 「毎日持ち歩きたくなる「ハーフサイズが新しい」クレンゼ加工のタオルハンカチ」プロジェクト詳細ページです。







